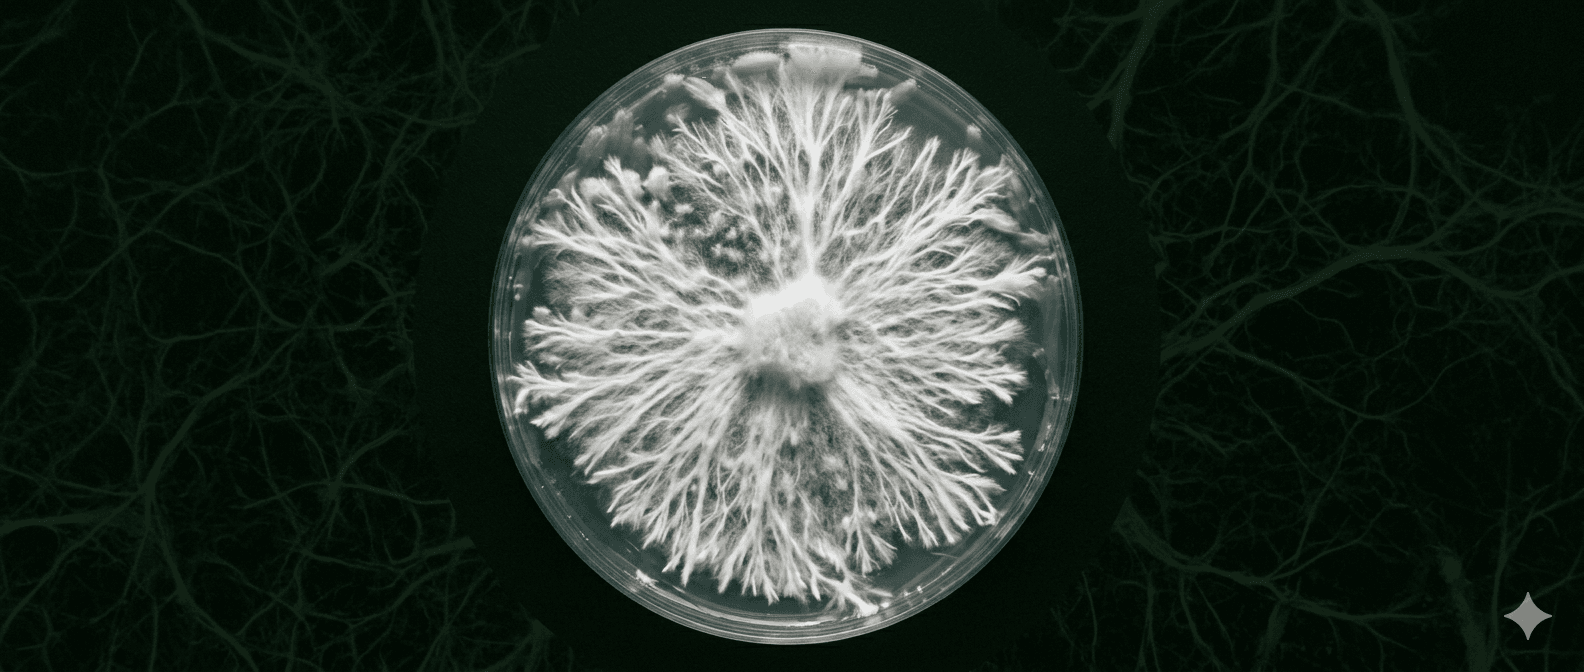

HONGOS. AGROECOLOGIA. ECOSISTEMAS. REFLEXIONES. PROPÓSITO. CURIOSIDADES. EL SALVADOR
Soy Jona Gomez, y este es mi espacio donde documento y comparto todo lo que hago en mi vida. Que mis experiencias iluminen tu camino actual.
Últimas entradas
 HONGOS
HONGOSCuatro días, una montaña rusa y un micelio que sabe adónde va
Leer → EMPRENDIMIENTO Y NEGOCIOS
EMPRENDIMIENTO Y NEGOCIOSNo estamos logrando distribuir el producto... Pero quizás haya una solución
Leer → AGROECOLOGIA
AGROECOLOGIACreación de Compost en Finca Amaviora: Desafíos y Beneficios de Regenerar nuestra Tierra en Santo Tomás
Leer → EMPRENDIMIENTO Y NEGOCIOS
EMPRENDIMIENTO Y NEGOCIOSUn sistema revolucionario para crear contenido mientras manejo
Leer →
Micelio y kits de cultivo
Productos disponibles para quienes quieren cultivar con criterio — desde micelio hasta insumos seleccionados.
Ver tiendaSobre mí
Soy Jonathan Gómez. Trabajo en la intersección entre biología de hongos, software y procesos ordenados — con curiosidad y sin humo. Este sitio reúne el blog, la tienda y herramientas para gestionar ambos mundos.